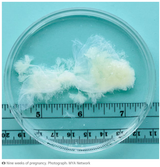

>>127384894
>>127384894
>She's more successful than you will ever be
naw bro
only by your definition of success, I guess.
having more money is a just an American way to judge success.
she has a lot less freedom and a lot more obligations than a lot of people could live with.
and she's in a very ugly and shady industry, too, as she's found out several times
she also has no children, which is THE biggest thing in life.
and like Drake or MJ, she's so famous that she can never trust that anyone likes her for being who she is, or for being "Taylor Swift".
And that applies doubly to those who have something to gain professionally from being associated with her, like football players, agents, model friends, other entertainment people, etc